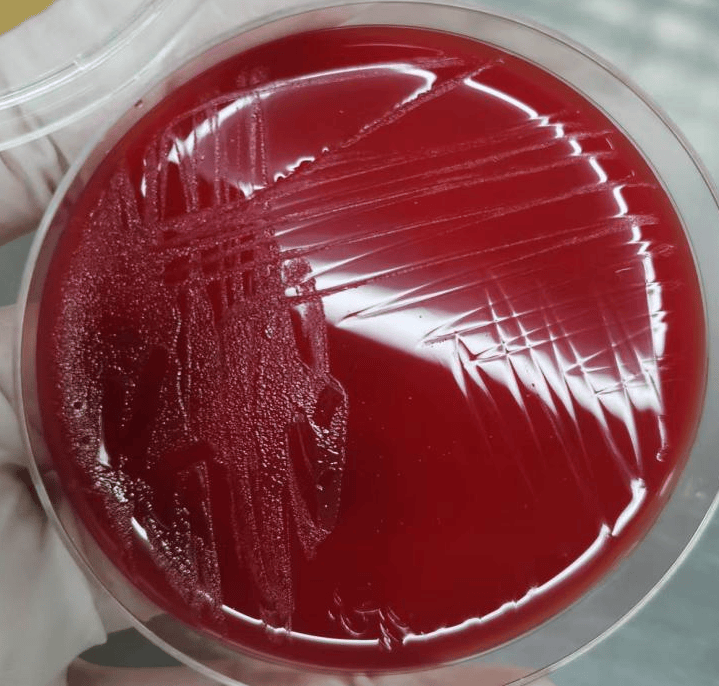
一布鲁氏菌感染病例分享及实验室诊断

布氏杆菌图片

🦠布鲁杆菌全解析🔍
图片尺寸1080x1410
一布鲁氏菌感染病例分享及实验室诊断
图片尺寸852x754
检验科镜检布氏杆菌阳性11
图片尺寸1080x1080
布鲁氏菌(革兰氏阴性细菌)
图片尺寸728x463
布氏杆菌病
图片尺寸272x240
类杆菌
图片尺寸1124x930
细菌|阴性|杆菌|培养物|布鲁氏菌
图片尺寸660x881
布鲁氏杆菌
图片尺寸1000x800
布氏杆菌
图片尺寸2000x2036
布氏杆菌
图片尺寸500x500
基层医院检出布鲁氏菌一例
图片尺寸681x650
布氏杆菌
图片尺寸906x1409
一布鲁氏菌感染病例分享及实验室诊断
图片尺寸719x686
涂片镜检可见短小的球杆菌,形态像似散在的细小沙粒样. 液体
图片尺寸1280x1706
形态结构革兰阴性短小杆菌.大小为长0.5
图片尺寸640x427
基层医院检出布鲁氏菌一例
图片尺寸717x650
布氏乳杆菌的彩色扫描电镜研究图片
图片尺寸800x698
喝牛奶惹的祸
图片尺寸370x209
布鲁菌:短小球杆菌,革兰染色阴性,着色弱 - 抖音
图片尺寸1220x1242
用药及体温变化情况五,最后诊断与诊断依据最后诊断:布氏杆菌感染诊断
图片尺寸824x1876